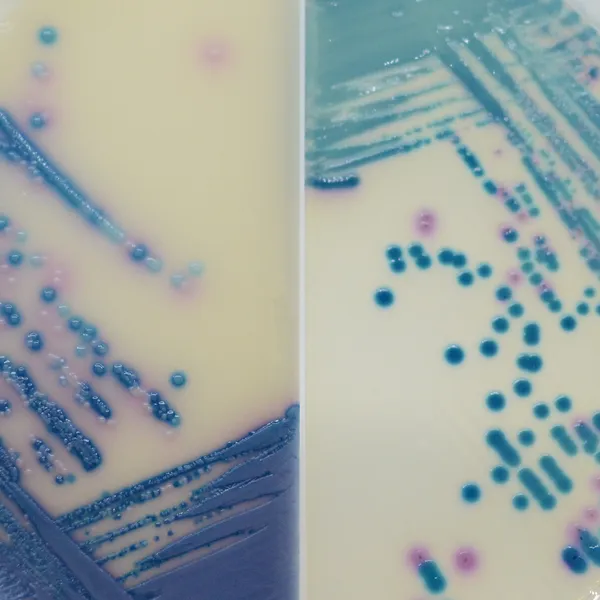
CHROMagar™ Mastitis

Colonies Appearance

CHROMagar™ Mastitis GP
S. agalactiae

CHROMagar™ Mastitis GP
S. uberis

CHROMagar™ Mastitis GP
S. aureus

CHROMagar™ Mastitis GN
Klebsiella, Enterobacter, Citrobacter

CHROMagar™ Mastitis GN
E. coli

CHROMagar™ Mastitis GN
Proteus

CHROMagar™ Mastitis GN
C. albicans
Performance
Performance
Lack of Mastitis infection’s spread control in cattle is known as a cause of heavy economic losses to milk producers and to the dairy industry. Mastitis causes a reduction in the quantity and quality of milk output, increased veterinary expenses due to excessive use of medications, increased risk of residues in the milk or meat and, consequently, the possibility of damage to public health.
Estimated costs per infection of clinical Mastitis go from $178 to $489 depending on milk prices, level of production in affected cows and stage of lactation when the disease occurred. In fact, the most common causes of antibiotic use in dairy cows are the treatment and prevention of mastitis.
In order to avoid the indiscriminate use of antibiotics in cattle and reduce the economic burden of clinical mastitis, it is critical to implement an on-farm rapid identification of milk pathogens.
CHROMagar™ Mastitis is a new commercially available tool for the rapid and simple differentiation of the main bacteria involved in Mastitis infections. It is supplied as a kit with two different media, one for the gram positive bacteria, and the other for the gram negative bacteria.
1. Colorful differentiation of the main pathogenic bacteria : Facilitating the choice of appropriate and optimized therapies.
2. 24 h detection : Minimizing the time to make the best treatment decisions.
3. Two-in-one plate : Allowing in one glance the identification of the whole spectrum of Gram (+) and Gram (-) bacteria.
Composition

Technical Documents
Scientific Publications
2021
Evaluation of chromogenic culture media for rapid identification of microorganisms isolated from cows with clinical and subclinical mastitis
📄 Publication2021
Evaluation of Chromogenic culture media for rapid identification of gram-positive bacteria causing mastitis
📄 Publication2022
3D-Printed Dip Slides Miniaturize Bacterial Identification and Antibiotic Susceptibility Tests Allowing Direct Mastitis Sample Analysis
📄 Publication

Read more